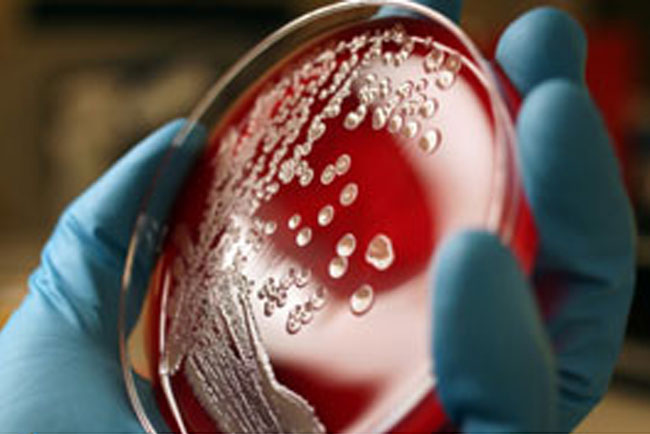

Los riesgos de los parabenos
Aunque no se ha demostrado de forma definitiva su toxicidad, la alarma social ha llevado a muchas firmas a retirar y sustituir los parabenos de sus productos. ¿Es real el riesgo?
-
Microagujas cosméticas: innovación al servicio de la piel
-
Glosario Cosmetología Actual
Un práctico repaso a los términos que definen la cosmetología actual
-
Mesoestetic lanza un nuevo parche diario busca acompañar el bienestar femenino durante la menopausia
La innovación combina tecnología transdérmica y una selección de activos específicos para ayudar a afrontar algunos de los síntomas más habituales de esta etapa.
-
La inteligencia artificial transforma el cuidado facial con una experiencia pionera de belleza tecnológica
Una innovadora actividad permitirá descubrir cómo la combinación de tecnología avanzada y asesoramiento especializado puede ayudar a personalizar las rutinas de cuidado de la piel.
-
CONCURSO BEAUTY MARKET ESTÉTICA
Conviértete en patrocinador del concurso que conecta tu marca con los profesionales de la imagen personal
Una oportunidad estratégica para posicionar tus productos directamente en manos de estilistas, barberos, esteticistas y especialistas del sector

Los parabenos son uno de los ingredientes más comunes en cosmética, gracias a su efectividad y bajo riesgo demostrado durante décadas de uso, además de su mínimo coste. Desde 1925 forman parte de la formulación de cremas, lociones, champús, maquillajes, lacas de uñas, lubricantes, e incluso forman parte de algunos alimentos, refrescos y medicamentos.
Sin embargo, en los últimos años ha surgido una gran preocupación sobre la posibilidad de que los parabenos resulten nocivos para la salud, y aunque los organismos oficiales no han prohibido su uso, la industria cosmética ha empezado a cambiar la composición de sus productos, sustituyendo los parabenos por otras alternativas y promoviendo sus nuevas fórmulas "libres de parabenos".
Pero, ¿de dónde surge el riesgo?

¿Qué son los parabenos?
Aunque existen una pequeña cantidad de parabenos de origen natural, por norma general, cuando hablamos de parabenos nos referimos a un compuesto químico creado artificialmente.
En las etiquetas de composición suelen aparecer con estos nombres: metilparaben (o E218), etilparaben (E214), propilparaben (E216), isopropilparaben, butilparaben, isobutilparaben y benzilparaben.
Su función en la formulación de cualquier producto suele ser como conservante, ya que previene la aparición de microorganismos como hongos o bacterias, y también evitan que las cremas pierdan su densidad y textura.
¿Son tóxicos los parabenos?
Oficialmente, no hay ningún estudio que lo demuestre, y ningún organismo oficial así lo ha decretado. De hecho, muchos estudios han demostrado que los parabenos ingeridos son metabolizados por el organismo y excretados muy fácilmente, sin dejar restos.
Fue en 2004, sin embargo, que saltó la alarma en el sector. Ese año, un equipo investigador de la Universidad de Reading (Edimburgo), liderado por la Dra. Philippa Darbre, publicó un estudio que relacionaba los tejidos cancerígenos con los parabenos: tras analizar varias muestras de mujeres con cáncer de mama, encontraron que en el 90% de ellas había rastros de parabenos.

Esto confirmaba algunos descubrimientos hechos en años anteriores, que afirmaban que los parabenos simulan en el organismo la acción de los estrógenos, la hormona femenina, y que al entrar en contacto con células mamarias infectadas con cáncer provocan que el tumor se desarrolle más rápidamente.
Según el equipo de la Dra. Darbre, el problema es que los parabenos aplicados a través de la piel no son metabolizados de la misma manera que los ingeridos, y se mantienen intactos en el cuerpo durante un lago plazo, acumulándose incluso en dosis bajas. A pesar de todo, los resultados no están considerados como definitivos, por lo que las autoridades sanitarias siguen manteniendo los parabenos en la lista de no tóxicos. Sin embargo, el revuelo que causó la llegada de esta información al público fue muy importante, e incluso se creó en 2005 un Comisión Europea para estudiar su prohibición, pero la falta de datos y de ensayos clínicos en seres humanos no permitió unos resultados claros.
Aunque siguen sin estar prohibidos, la Comisión Europea sí recomendó a la Unión Europea que no autorizara un aumento de los niveles de parabenos en los nuevos productos, y frente a la preocupación de la sociedad, la reacción del sector cosmético fue inmediata.
La respuesta de los fabricantes
El equipo de la Dra. Darbre insiste en la necesidad de una investigación más detallada de los parabenos y sus efectos en la salud pública, puesto que su amplio uso en multitud de productos podría suponer un gran riesgo en caso de demostrar de manera definitiva su toxicidad y su contribución al incremento del cáncer de mama.
Frente a esta situación, y mientras no existan estudios y regulaciones oficiales, la industria cosmética ha decidido apostar por la prevención, y ha empezado a sustituir los parabenos de sus productos, sustituyéndolos por otros conservantes libres de controversia como el ácido ascórbico (vitamina C). Así, son muchas las firmas que han reformulado la composición de sus productos, y se pueden encontrar en el mercado muchos nuevos cosméticos con la etiqueta "libre de parabenos".
De todos modos, el usuario del producto tampoco debe dejar de lado su autoprotección, por lo que debe leer con atención las etiquetas de sus productos para asegurarse de que no incluyen ingredientes tóxicos o potencialmente peligrosos.

Recomendamos




















